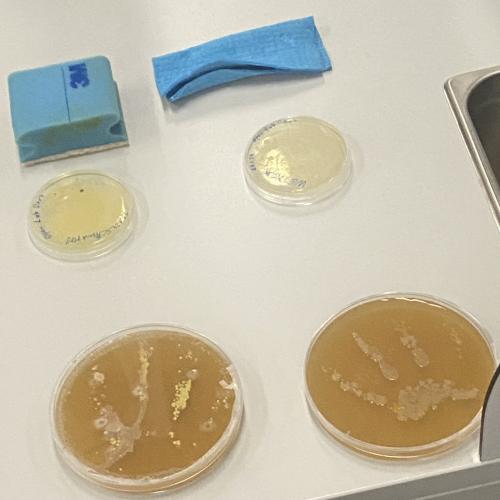
open lab

Open Lab Days
Einen ersten Einblick bekam ein Teil der 7c-Klasse am 6.2.2024, als sie die Möglichkeit ergriffen, an den Open Lab Days der Medizinischen Universität Innsbruck zum Thema „Molekularmedizin“ teilzunehmen.
Nach einer kurzen Einführung in den Studienbereich, erwarteten uns einige spannende Vorträge. Vom „Wunder Zelle“, „Schimmelpilzen“ oder auch „Unser geheimnisvolles Gehirn“, erhielten die Schüler: innen einen vielfältigen Einblick durch die Lektor:innen.
Es kam aber auch der praktische Teil nicht zu kurz. Das Interesse der Schüler: innen wurde vor allem während der Arbeit in den Laboren geweckt, bei dem sie ihr Können unter Beweis stellen konnten. Ein 3D-Drucker zur Nachbildung von Muskelringen, richtige Handhygiene sowie Zellbestandteile unterm Mikroskop, sind nur ein kleiner Ausschnitt aus der Vielzahl der durchgeführten Versuche.
Aya Rashidova, Hanna Gratt, 7c